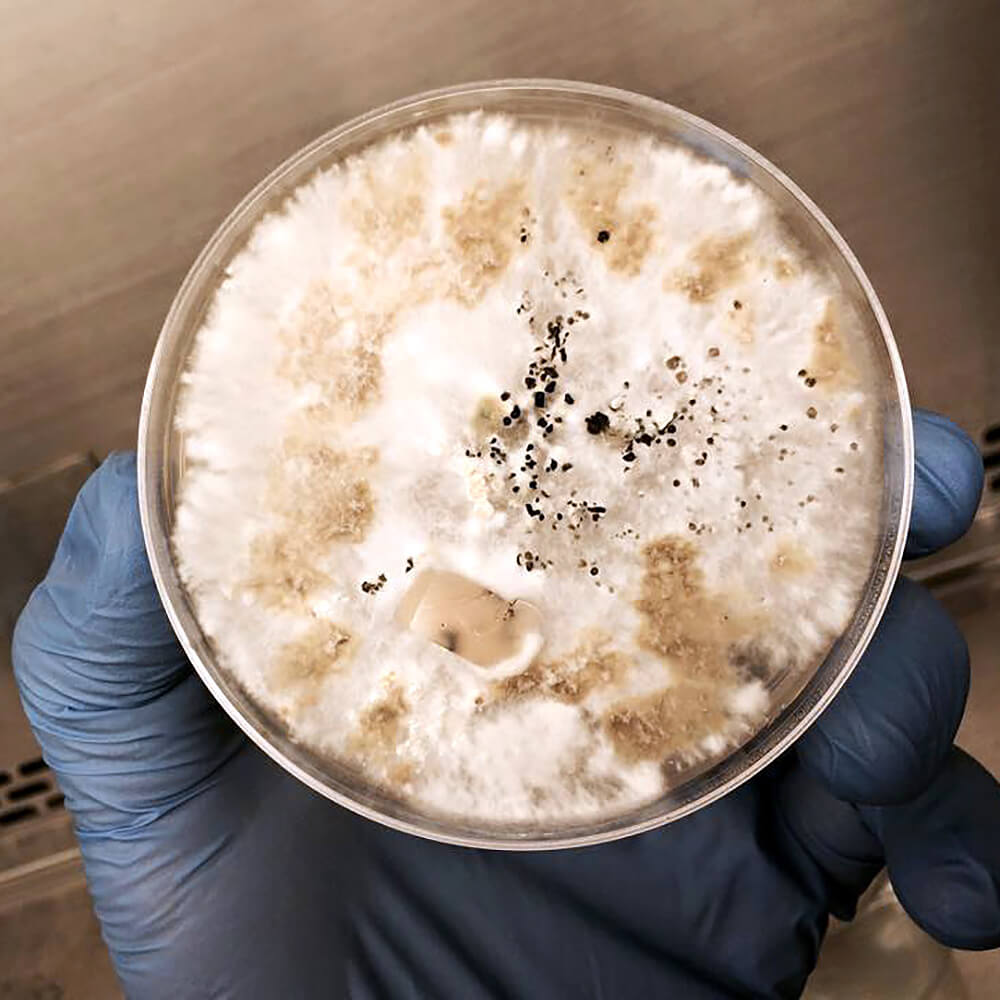

All products
Welcome to Out-Grow’s complete range of mushroom cultivation products. Whether you're a hobbyist or a seasoned grower, we offer everything you need to successfully cultivate mushrooms at home or on a larger scale. Browse our diverse selection of mushroom cultures, substrates, grow kits, and tools to help your cultivation thrive. Each product is carefully crafted to ensure quality, reliability, and optimal results for your growing journey.
2 Sterilized Rye Bags with Injection Port & 1 Bag of 5lb Manure Substrate
5.0 / 5.0
4 reviews
$25.95